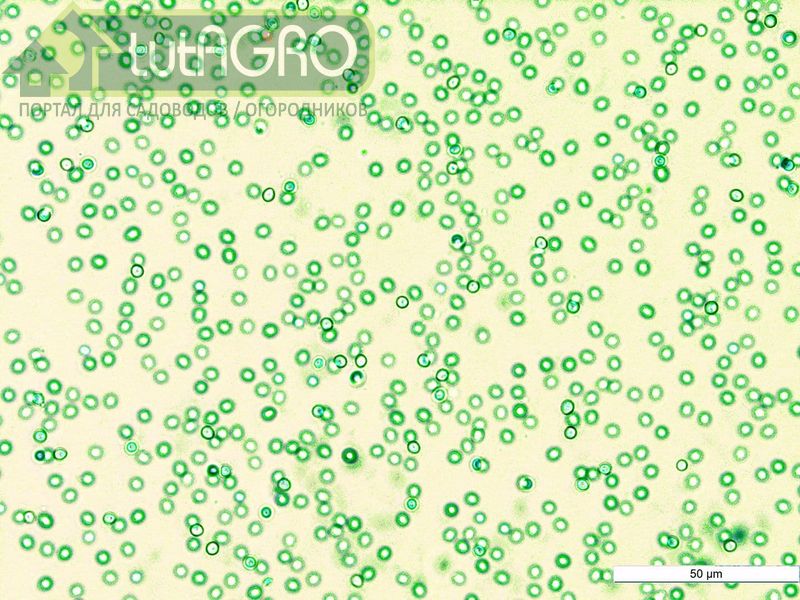

Стремление к экологически чистому земледелию неизбежно приводит к замене синтетических химических препаратов на более дружественные природе биопрепараты. Однако применяя биопрепараты для эффективного подавления патогенной микрофлоры одновременно можно нанести вред и полезным почвенным микроорганизмам. Как соблюсти баланс между пользой и вредом при применении биопрепаратов?
Одним из наиболее распространенных и часто применяемых биопрепаратов является Фитоспорин-М. Это препарат на основе сенной палочки, применяемый для лечения и профилактики грибных и бактериальных заболеваний (фитофтороза, корневой гнили, мучнистой росы и др.). При этом в различных исследованиях показано, что бактерии Фитоспорина могут активно подавлять и полезную микрофлору почвы. Особенно ярко этот негативный эффект проявляется в полевых условиях. Под удар попадают грибы рода Триходерма, азотфиксаторы Ризобиум, Азотобактер и др. Снижается и разнообразие, и общая численность, и активность полезных растениям микроорганизмов, а в итоге - страдает урожай.

Варианты использования препарата Фитоспорин без ущерба для урожая:
Первый вариант - разделение в пространстве. Например, Триходерму и Азотобактера использовать под корень, а сенной палочкой обрабатывать по листу.
Второй вариант - разделение во времени. Например, внести препарат сенной палочки в почву и по листу одновременно, а препарат с Триходермой или другими микроорганизмами - не раньше, чем через две недели. Чередование препаратов окажет на растение весь комплекс полезных свойств.
Третий вариант - совмещение первого и второго. Например, по листу обработать сенной палочкой, а в почву внести Триходерму, а через две недели - наоборот: пролить сенной палочкой и опрыскать Триходермой. Такой комплексный подход не позволит вредным микроорганизмам приспособиться к воздействию биопрепаратов, растения получат уход и защиту, при этом полезная аборигенная микрофлора сможет восстанавливаться после каждой обработки без ущерба для урожая.
Есть еще и четвертый вариант - подбирать более профессиональные препараты, которые обладают высокой активностью против патогенов и дружественны полезной микрофлоре. Например, препараты Бактоген (сенная палочка), Стимул, Гулливер, Азофит, Азотовит, Фосфатовит и Калийвит полностью совместимы. При этом Бактоген легко расправляется с вредными псевдомонадами (возбудителями пятнистостей и гнилей овощей, бактериального ожога плодовых) и эрвиниями (возбудители бактериального рака плодовых, черной ножки томата и картофеля). Несмотря на такую дружбу с полезными бактериями, даже Бактоген не стоит смешивать с Триходермой. Ведь Бактоген - очень мощный противогрибковый препарат и с легкостью уничтожает не только патогенные грибки, но подавляет рост даже самой быстрорастущей Триходермы.
Автор: Иван РУССКИХ














